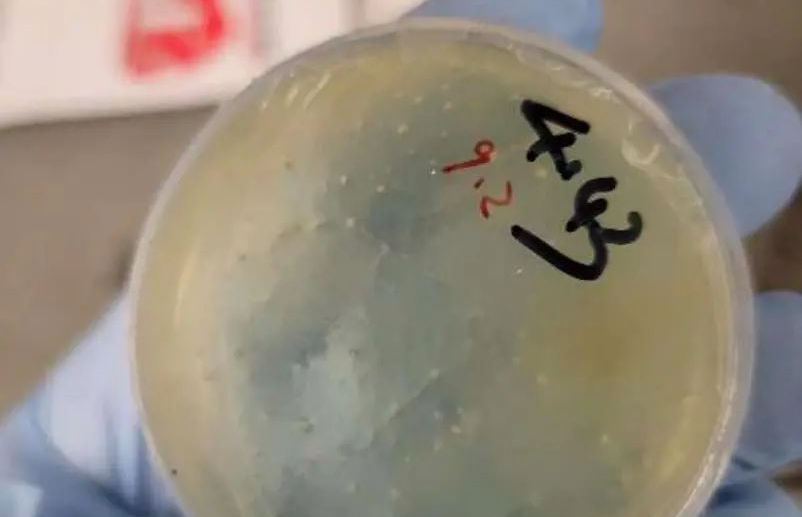

Another Chinese national arrested for smuggling ‘roundworms’ into US University of Michigan
Another Chinese scientific researcher has been arrested and charged with smuggling biological materials into the United States for use in a University of Michigan laboratory, intensifying a growing agroterrorism investigation involving foreign nationals.
Chengxuan Han, a Chinese national, has been accused of smuggling roundworms into the US and making false statements, according to an announcement from the United States Attorney's Office for the Eastern District.
Han is currently pursuing a PhD from the College of Life Science and Technology at Huazhong University of Science and Technology in Wuhan, China.
The federal complaint states that in 2024 and 2025, Han shipped four packages from China to individuals affiliated with a laboratory at the University of Michigan.
These packages contained concealed biological material. Authorities say Han arrived at Detroit Metropolitan Airport on June 8, 2025, on a J1 visa.
During a customs inspection, Han allegedly lied about the nature of the packages and denied having sent any biological materials to the United States.
Customs and Border Protection (CBP) officers found that Han's electronic devices had been wiped clean three days before her arrival.
After the inspection, Han was interviewed by FBI agents.
She reportedly admitted to having sent the packages and confirmed that they contained biological materials related to roundworms.
Han also acknowledged that she provided false information to CBP officers during the inspection.
Han is scheduled to appear in federal court in Detroit on Monday afternoon.
“The alleged smuggling of biological materials by this alien from a science and technology university in Wuhan, China -- to be used at a University of Michigan laboratory -- is part of an alarming pattern that threatens our security,” said US Attorney Jerome F Gorgon, Jr in a statement.
“The American taxpayer should not be underwriting a PRC-based smuggling operation at one of our crucial public institutions,” he added.
The FBI, CBP, and US Immigration and Customs Enforcement's Homeland Security Investigations (ICE HSI) are jointly investigating the case.
Officials have indicated that this incident is part of a broader inquiry into agroterrorism-linked smuggling by Chinese researchers at American institutions.
Previously, two Chinese nationals were charged in a separate but related case involving the smuggling of Fusarium graminearum, a biological pathogen considered a potential agroterrorism agent.
The fungus is known to cause head blight in cereal crops, resulting in billions of dollars in agricultural losses.
It also produces toxins that can affect both human and animal health by inducing vomiting, liver damage, and reproductive issues.
According to an FBI criminal complaint, 34-year-old Zunyong Liu brought the pathogen into the US in July 2024 during a visit to his girlfriend, 33-year-old Yunqing Jian.
Liu later admitted to transporting the fungus to conduct research at the same University of Michigan laboratory where Jian worked.
Federal authorities found electronic communications between the two that confirmed their collaboration, leading to charges of conspiracy, smuggling, false statements, and visa fraud.
Investigators also discovered that Jian had received Chinese government funding for research on the pathogen and that her devices contained evidence of her ties to the Chinese Communist Party.
Cheyvoryea Gibson, Special Agent in Charge of the FBI Detroit Field Office, emphasised the seriousness of the case, stating that the pair’s actions posed “an imminent threat to public safety.”
As concerns mount over the implications of biological smuggling, US authorities continue to investigate potential threats to national security, agriculture, and public health.
(This story was taken from a syndicated feed and was only edited for style by Gujarat Samachar Digital team)

